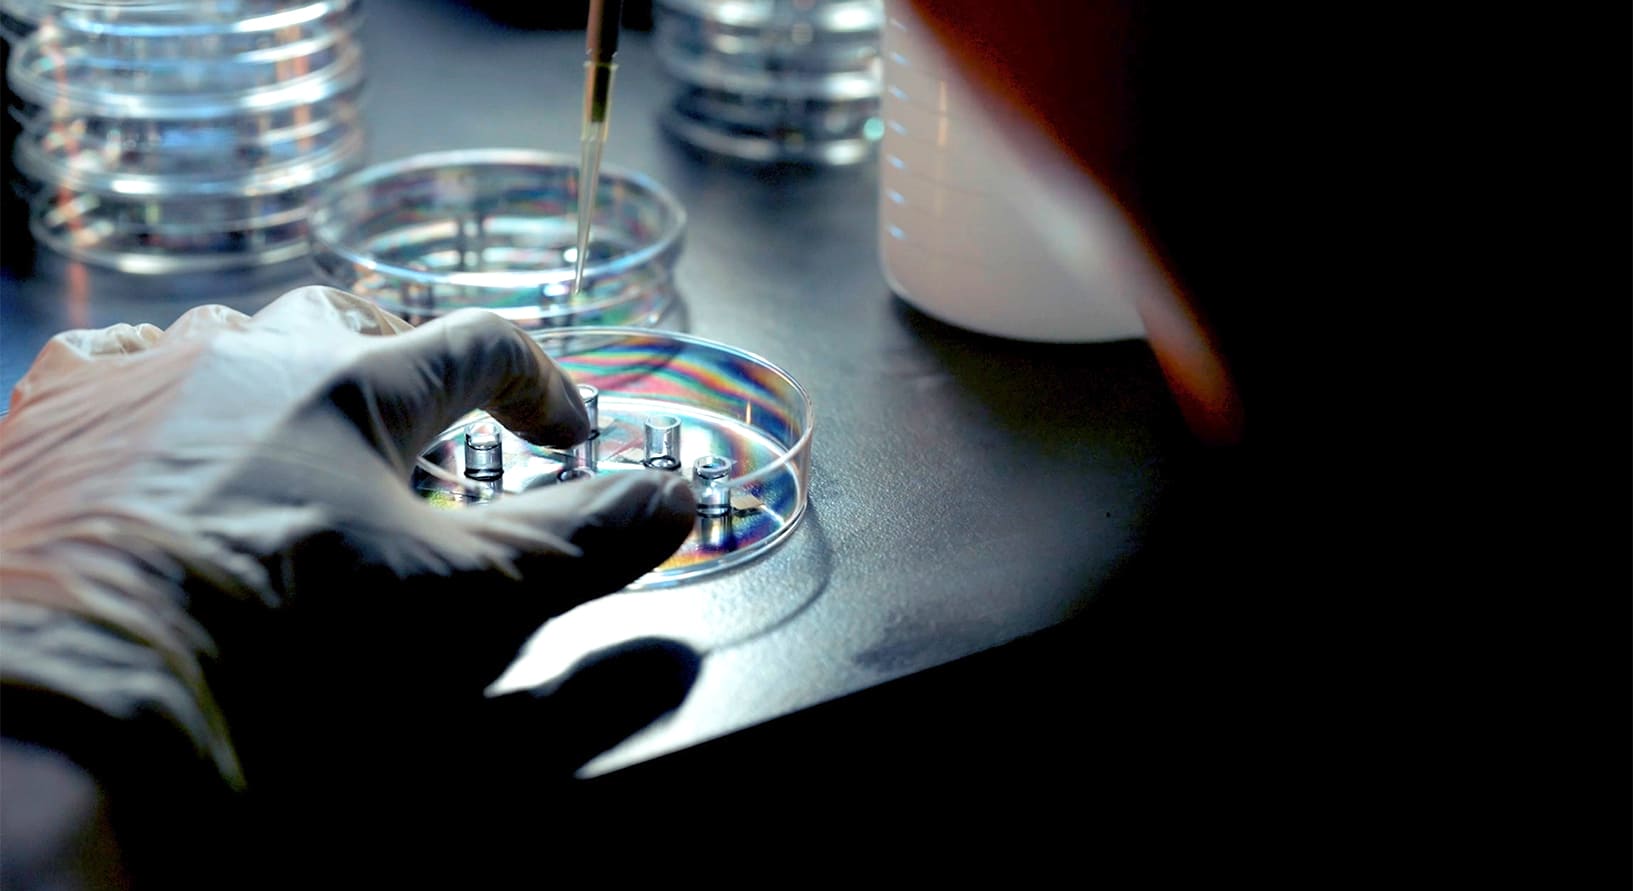
写真：実験風景

未来を拓くバイオミメティクス
重点研究課題:
(5)
研究主体:
生体医工学研究センター
研究代表者:
合田 達郎 教授(生命科学部生体医工学科)
研究期間:
2024年4月~2027年3月

「バイオミメティクス」とは、生物が進化の過程で獲得してきた分子・構造・機能・生産方法・物質循環・情報処理から着想を得て、それらを科学や医学、産業などのものづくりの分野に生かす概念である。現在、東洋大学の生体医工学分野を中心に、工学や水産学、地球環境科学から、教育学、哲学まで、文理融合でバイオミメティクスの研究に取り組み、SDGsの達成へ貢献することを目指している。
取材:2024年7月
「バイオミメティクス」とは、生物が進化の過程で獲得してきた分子・構造・機能・生産方法・物質循環・情報処理から着想を得て、それらを科学、医学、産業などのものづくりの分野に生かす概念です。“生物に倣(なら)う“という発想は、ものづくりのあらゆる場面において活用され始め、さまざまな研究分野、産業界に影響を与え、SDGsの実現にも貢献すると期待されています。
具体的な研究としては、生体と人工物の境目で起こるさまざまな生体反応を制御して目的の応答を得るためにバイオミメティクス技術を活用してきました。現在は生体系の物質循環に倣い、希少元素を用いることなく汎用性元素のみから構成される導電性有機材料に立脚し、軽量・安価かつ高機能なウエアラブルバイオセンサ開発を通して安全安心社会の実現を目指しています。
また人工知能の分野では、ニューラルネットワーク解析の研究が進められています。これは人間の脳の情報処理に倣った解析であり、バイオミメティクス技術とみることができます。総合情報学部では、AIを用いて病気のリスクや未病状態を判別診断するシステムを開発し、新しい治療法の提案につなげています。
実は、本プロジェクトが推進するこれらのバイオミメティクス研究の土台には、東洋大学の創設者である井上円了の自然界を含む万物を自らの教師とする「活書活学」という考え方があります。東洋大学で文系理系の垣根を超えて総合的にバイオミメティクスの研究に取り組むことは、人間のみならず生物すべての命を尊重することの価値を再発見・再定義し、人類の明るい未来を拓くための第一歩として大きな意義を持っています。

東洋大学生命科学部生体医工学科教授、本研究プロジェクト代表者。
東京大学工学系研究科マテリアル工学専攻博士課程修了。日本学術振興会特別研究員、2011年に東京医科⻭科⼤学⽣体材料⼯学研究所助教、2012年にスウェーデンのカロリンスカ研究所客員研究員、2020年より東洋大学理工学部准教授などを経て2024年4月から現職。生物が持つ構造や機能などを解明して新たな技術を生み出す「バイオミメティクス(生物模倣)」の活用による高機能なものづくりなどの研究に取り組む。
※研究代表者の所属・職位は、取材時と異なっている場合があります。